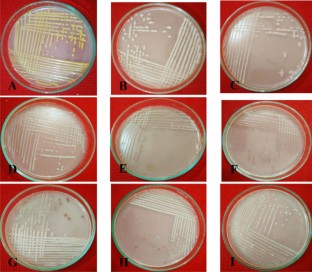

Abstract
The present investigation was carried out to investigate the effects of rhizosphere bacteria on growth and rice yields. Also, isolation and identification of rhizospheric bacterial treatments rhizosphere soil, mixed bulk, and fertilized soils. Soil analysis showed a maximum pH of 8.46 in rhizosphere soil of Sada dhepa. Nitrogen content of the rhizosphere soil of Latif sayil showed 0.18% maximum result. In-plant growth and yield, 87.37 cm leaf length, 28.83 cm panicle length, and 2.32 gm 100 seed weight in rhizosphere soil of Latif sayil were observed. Five different rhizobial bacteria Rhizobium tropici, Rhizobium leguminosarum, Rhizobium freirei, Rhizobium oryzae, Bacillus subtilis were isolated from the rhizosphere. Mixed treatment on Azospirillum largimobile, Azotobacter chroococcum, Rhizobium leguminosarum, Pseudomonas fluorescens were isolated from the rhizosphere. Mixed treatment was significantly similar to Rhizobium tropici and Azotobacter chroococcum by a maximum of 82.32% and 86.19%, respectively. Our results indicate that selected rhizobial strains promote rice growth and yields that could be harnessed to practical benefit for the farmer and are consistent with sustainable agricultural practices.

Similar content being viewed by others
References
Asghar HN, Zahir AZ, Abdul K, Muhammad A (2000) Assessment of auxin production from rhizobacteria isolated from different varieties of rapeseed. Pak J Agri Sci 37(3–4):101
Barillot CD, Sarde CO, Bert V, Tarnaud E, Cochet N (2013) A standardized method for the sampling of rhizosphere and rhizoplan soil bacteria associated to a herbaceous root system. Ann Microbiol 63(2):471–476
Bird BW, Mark B, Abbott DT, Rodbel MV (2011a) Holocene tropical South American hydroclimate revealed from a decadally resolved lake sediment δ18O record. Earth Planet Sci Lett 310(3–4):192–202
Bird JA, Herman DJ, Firestone MK (2011b) Rhizosphere priming of soil organic matter by bacterial groups in a grassland soil. Soil Biol Biochem 43(4):718–725
Biswas JC, Ladha JK, Dazzo FB, Yanni YG, Rolfe BG (2000) Rhizobial inoculation influences seedling vigor and yield of rice. Agron J 92(5):880–886
Bradford MA, Fierer N, Reynolds JF (2008) Soil carbon stocks in experimental mesocosms are dependent on the rate of labile carbon, nitrogen and phosphorus inputs to soils. Funct Ecol 22(6):964–974
Burney JA, Davis SJ, Lobell DB (2010) Greenhouse gas mitigation by agricultural intensification. Proc Natl Acad Sci 107(26):12052–12057
Cai Z, Xing G, Yan X, Xu H, Tsuruta H, Yagi K, Minami K (1997) Methane and nitrous oxide emissions from rice paddy fields as affected by nitrogen fertilisers and water management. Plant Soil 196(1):7–14
Chabot R, Antoun H, Cescas MP (1996) Growth promotion of maize and lettuce by phosphate-solubilizing Rhizobium leguminosarum biovar. Phaseoli Plant Soil 184:311–321. https://doi.org/10.1007/BF00010460
Cheng W, Kuzyakov Y (2005) Root effects on soil organic matter decomposition. Roots Soil Manag 48:119–143
Collignon C, Uroz S, Turpault MP, Frey-Klett P (2011) Seasons differently impact the structure of mineral weathering bacterial communities in beech and spruce 2012–stands. Soil Biol Biochem 43:2022
Cook RJ, Thomashow LS, Weller DM, Fujimoto D, Mazzola M, Bangera G, Kim DS (1995) Molecular mechanisms of defense by rhizobacteria against root disease. Proc Natl Acad Sci 92(10):4197–4201
De Angelis KM, Ji P, Firestone MK, Lindow SE (2005) Two novel bacterial biosensors for detection of nitrate availability in the rhizosphere. Appl Environ Microbiol 71(12):8537–8547
Gandhi A, Sivakumar K (2010) Impact of vermicompost carrier based bioinoculants on the growth, yield and quality of rice (Oryza sativa L.) CV NLR 145. Ecoscan 4(1):83–88
Gelaw AM, Singh BR, Lal R (2015) Soil quality indices for evaluating smallholder agricultural land uses in northern Ethiopia. Sustainability 7(3):2322–2337
Guimaraes AA, Jaramillo PMD, Nobrega RSA, Florentino LA, Silva KB, de Souza Moreira FM (2012) Genetic and symbiotic diversity of nitrogen-fixing bacteria isolated from agricultural soils in the western Amazon by using cowpea as 6726 the trap plant. Appl Environ Microbiol 78:6733
Hafeez K, Yan BZ, Naila M (2002) Determining key capabilities of a firm using analytic hierarchy process. Int J Prod Econ 76(1):39–51. https://doi.org/10.1016/S0925-5273(01)00141-4
Herron PM, Gage DJ, Cardon ZG (2010) Micro-scale water potential gradients visualized in soil around plant root tips using microbiosensors. Plant Cell Environ 33:199–210
Hinsinger P, Bengough AG, Vetterlein D, Young IM (2009) Rhizosphere: biophysics, biogeochemistry and ecological relevance. Plant Soil 321(1–2):117–152
Hoeflich P, Khokhlov AM, Wheeler JC (1995) Delayed detonation models for normal and subluminous type IA sueprnovae: absolute brightness, light curves, and molecule formation. Astrophys J 444(2):831–847
Iatrou M, Papadopoulos A, Papadopoulos F, Dichala O, Psoma P, Bountla A (2014) Determination of soil available phosphorus using the Olsen and Mehlich 3 methods for Greek soils having variable amounts of calcium carbonate. Commun Soil Sci Plant Anal 45(16):2207–2214
Jorquera MA, Shaharoona B, Nadeem SM, de la Luz MM, Crowley DE (2012) Plant growth-promoting rhizobacteria associated with ancient clones of creosote bush (Larrea 1008–tridentata). Microb Ecol 64:1017
Juhnke M, Elliott DE, Mathre DC, Sands D, Sands C (1987) Identification and characterization of rhizosphere-competent bacteria of wheat. Appl Environ Microbiol 53(12):2793–2799. https://doi.org/10.1128/AEM.53.12.2793-2799
Khalil MAK, Rasmussen RA, Shearer MJ, Chen ZL, Yao H, Yang J (1998) Emissions of methane, nitrous oxide, and other trace gases from rice fields in China. J Geophys Res 103(D19):25241–25250
Khammas KM, Kaiser P (1991) Characterization of a pectinolytic activity in Azospirillum irakense. Plant Soil 137(1):75–79
Kim DG, Thomas AD, Pelster D, Rosenstock TS, Sanz-Cobena A (2015) Greenhouse gas emissions in natural and agricultural lands in sub-Saharan Africa: synthesizing of available data and suggestions for further studies. In: AGU Fall Meeting Abstracts.
Kloepper JW, Scher FM, Laliberté M, Tipping B (1986) Emergence-promoting rhizobacteria: description and implications for agriculture. In: Swinburne TR (ed) Iron, siderophores, and plant diseases. NATO ASI Series (Series A: life sciences), vol 117. Springer, Boston. https://doi.org/10.1007/978-1-4615-9480-2.17
Ladha JK, Pareek RP, So RB, Becker M (1990) Stem nodule symbiosis and its unusual proper ties. In: Gresshoff Roth LE, Stacey G, Newton WL (eds) N2 fixation: achievements and objectives. Chapman and Hall, New York, pp 633–640
Mapelli F, Marasco R, Balloi A, Rolli E, Cappitelli F, Daffonchio D, Borin S (2012) Mineral-microbe interactions: biotechnological potential of bioweathering. J Biotechnol 157:473–481
Marenya PP, Barrett CB (2009) State-conditional fertilizer yield response on western Kenyan farms. Am J Agr Econ 91(4):991–1006
Mari GR, Changying J, Zhou jun (2008) Effects of soil compaction on soil physical properties and nitrogen, phosphorus, potassium uptake in wheat plants [J]. Trans Chin Soc Agric Eng 24(1):74–79
Mehboob I, Zahir ZA, Arshad M, Tanveer A, Azam F (2011) Growth promoting activities of different Rhizobium spp. in wheat. Pak J Bot 43(3):1643–1650
Noel JB, Ghossain MA, Hugol D, Hassen K (1996) Characterization of adnexal masses: combination of color Doppler and conventional sonography compared with spectral Doppler analysis alone and conventional sonography alone. Am J Roentgenol 166:385–393. https://doi.org/10.2214/ajr.166.2.8553953
Peng S, Biswas JC, Ladha JK, Gyaneshwar P, Chen Y (2002) Influence of rhizobial inoculation on photosynthesis and grain yield of rice. Agronomy 94:925–929
Ramos C, Molbak L, Molin S (2000) Bacterial activity in the rhizosphere analyzed at the single-cell level by monitoring ribosome contents and synthesis rates. Appl Environ Microbiol 66:801–809
Raudales RE, Stone E, McSpadden Gardener BB (2009) Seed treatment with 2,4-diacetylphloroglucinol-producing pseudomonads improves crop health in low-pH soils by altering patterns of nutrient uptake. Phytopathology 99:506–511
Saitou N, Nei M (1987) The neighbor-joining method: a new method for reconstructing phylogenetic trees. Mol Biol Evol 4(4):406–425. https://doi.org/10.1093/oxfordjournals.molbev.a040454
Sampanpanish P (2012) Effect of organic fertilizer use in rice paddy to reduce greenhouse gases. Int Conf Environ Agric Eng IPCBEE 38:323
Shirley M, Avoscan L, Bernaud E, Vansuyt G, Lemanceau P (2011) Comparison of iron acquisition from Fe-pyoverdine 731–by strategy I and strategy II plants. Botany 89:735
Srinivasan R, Karaoz U, Volegova M (2015) Use of 16S rRNA gene for identification of a broad range of clinically relevant bacterial pathogens. PLoS ONE 10(2):e0117617. https://doi.org/10.1371/journal.pone.0117617
Van Loon L, Bakker PAHM (2003) Signalling in rhizobacteria-plant interactions. Root ecology. Springer, Berlin, pp 297–330
Vargas WA, Wippel R, Goos S, Kamper J, Sauer N (2011) Plant-derived sucrose is a key element in the symbiotic association between Trichoderma virens and maize plants. Plant Physiol 151:792–808
Walkley A, Black IA (1934) An examination of the Degtjareff method for determining soil organic matter, and a proposed modification of the chromic acid titration method. Soil Sci 37(1):29–38
Wang Y, Ohara Y, Nakayashiki H, Tosa Y, Mayama S (2005) Microarray analysis of the gene expression profile induced by the endophytic plant growth-promoting rhizobacteria, Pseudomonas fluorescence FPT9601-T5 in Arabidopsis. Mol Plant Microbe Interact 18(5):385–396
Yanni YG, Youssef G, Yanni FB, Dazzo FB, Dazzo M, Zidan I (2011) Beneficial endophytic rhizobia as biofertilizer inoculants for rice and the spatial ecology of this bacteria–plant association. Bacteria in agrobiology: crop ecosystems. Springer, Berlin. https://doi.org/10.1007/978-3-642-18357-7.10
Zhang H, Sun Y, Xie X, Kim MS, Dowd SE, Pare PW (2009) A soil bacterium regulates plant acquisition of iron via deficiency-inducible mechanisms. Plant J 58:568–577
Zhang F, Shen J, Zhang J, Zuo Y, Li L, Chen X (2010) Rhizosphere processes and management for improving nutrient use efficiency and crop productivity: implications for China. Adv Agron 107:1–32. https://doi.org/10.1016/S0065-2113(10)07001-X
Zhang X, Yin S, Li Y, Zhuang H, Li C, Liu C (2014) Comparison of greenhouse gas emissions from rice paddy fields under different nitrogen fertilization loads in Chongming Island, Eastern China. Sci Total Environ 472:381–388
Acknowledgements
The authors are thankful to the Ministry of Education, Government of the People's Republic of Bangladesh, for providing financial support during the research works (Grant no. LS20191063, 2018-2021).
Author information
Authors and Affiliations
Contributions
The study concept and design, developed methodology and the manuscript revision was performed by SN and MAI. The experimental samples collection, investigation, data analysis and the manuscript writing was performed by SN. The study implementation and manuscript revision was performed by MFH, BS and MAI. All authors read and approved the final manuscript.
Corresponding author
Ethics declarations
Conflict of interest
The authors declare that they have no conflict of interest.
Human and animal rights
This article involving no human and animal studies are presented in this manuscript by any of the authors.
Additional information
Publisher's Note
Springer Nature remains neutral with regard to jurisdictional claims in published maps and institutional affiliations.
Rights and permissions
About this article
Cite this article
Nahar, S., Hasan, M.F., Sikdar, B. et al. Effect of rhizosphere microbiome on different crop growing fields in various rice cultivars and its molecular approaches for sustainable agro-ecosystem. J. Crop Sci. Biotechnol. 24, 521–531 (2021). https://doi.org/10.1007/s12892-021-00099-0
Accepted:
Published:
Issue Date:
DOI: https://doi.org/10.1007/s12892-021-00099-0




